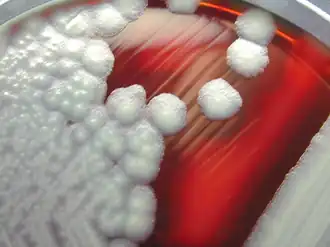
Colônias de B. cereus em placa de ágar com sangue de carneiro.

Bacillus cereus
Bacillus cereus
| |||||||||||||||
|---|---|---|---|---|---|---|---|---|---|---|---|---|---|---|---|
![]() Colônias de B. cereus em placa de ágar com sangue de carneiro. | |||||||||||||||
| Classificação científica | |||||||||||||||
| |||||||||||||||
| Nome binomial | |||||||||||||||
| Bacillus cereus Frankland & Frankland, 1887 | |||||||||||||||
O Bacillus cereus é uma bactéria beta-hemolítica gram-positiva, de forma cilíndrica, endêmica, que vive no solo. Algumas cepas são prejudiciais aos seres humanos e causam intoxicação alimentar, enquanto outras cepas podem ser benéficas, como os probióticos para animais.[1] É a causa da "síndrome do arroz frito", como as bactérias são classicamente contraídas a partir de pratos de arroz frito que têm estado à temperatura ambiente por horas (tal como em um 'buffet').[2] As bactérias B. cereus são organismo aerobicos facultativos, e tal como outros membros do gênero Bacillus, podem produzir endósporos protetores. Seus fatores de virulência incluem a cereolisina e a fosfolipase C.
Simbiose
A B. cereus compete com outros microrganismos, tais como a Salmonella e a Campylobacter no intestino, por isso sua presença reduz o número desses microorganismos.
Em rações animais, tais como as de galinha,[3] coelhos[4] e porcos,[5] algumas cepas inofensivas da B. cereus são usadas como probiótico aditivo para reduzir a Salmonella no intestino e no ceco. Isso melhora o crescimento dos animais, bem como a segurança alimentar para os seres humanos que comem sua carne.
Patogênese

A B. cereus é responsável por uma minoria de doenças transmitidas por alimentos (2-5 %), causando grave náusea, vômito e diarreia.[6] A intoxicação alimentar transmitida por bacilos ocorre devido à sobrevivência dos endo-esporos bacterianos quando o alimento é mal cozido.[7] As temperaturas de cozimento menores ou igual a 100 °C permitem que alguns esporos da B. cereus sobrevivam.[8] Este problema é agravado quando o alimento é então indevidamente refrigerado, permitindo aos endósporos germinar.[9] Os alimentos cozidos não destinados para consumo imediato ou para aquecimento e resfriamento rápidos devem ser mantidos em temperaturas acima de 60 °C.[8] A germinação e o crescimento ocorre geralmente entre 10 °C e 50 °C,[8] embora algumas cepas sejam psicrotróficas (crescem no frio).[10] O crescimento bacteriano resulta na produção de enterotoxinas, uma das quais é altamente resistente ao calor e ao pH entre 2 e 11.[11] A ingestão leva a dois tipos de doenças, diarreia e síndrome emética (vômitos).[12]
- * O tipo diarreico está associado à uma vasta gama de alimentos, tem um período de incubação de 8 à 16,5 horas e está associado com diarreia e dor gastrointestinal. Também conhecido como a forma de incubação longa da intoxicação alimentar por B. cereus, pode ser difícil de diferenciar de envenenamento causado por Clostridium perfringens;[11]
- * A forma emética é geralmente causada por arroz que não é cozido durante um tempo e temperatura suficientes para matar quaisquer esporos presentes, então impropriamente refrigerados. Pode produzir uma toxina, a cereulide, que não é desativada por reaquecimento posteiror. Esta forma leva a náuseas e vômitos 1-5 horas após o consumo. Pode ser difícil de distinguir de outros patógenos alimentares bacterianos de curto prazo tais como o Staphylococcus aureus.[11]
As síndromes diarreicas observadas nos pacientes são vistas como o resultado de três toxinas: a hemolisina BL Hbl, a enterotoxina não-hemolítica Nhe e a citotoxina K CytK.[13] Os genes nhe / hbl / cytK estão localizados no cromossomo da bactéria. A transcrição destes genes é controlada por PlcR. Estes genes também ocorrem nas toxonomicamente relacionadas B. thuringensis e B. anthracis. Estas enterotoxinas são todas produzidas no intestino delgado do hospedeiro, deste modo frustrando a saída da digestão por enzimas endógenas hospedeiras. As toxinas HBL e Nhe são toxinas formadoras de poros estreitamente relacionadas com a ClyA da E. coli. As proteínas apresentam uma conformação conhecida como "barril beta" que pode se inserir em membranas celulares devido a um exterior hidrofóbico, deste modo criando poros com interiores hidrofílicos. O efeito é a perda de potencial elétrico de membrana celular e eventualmente morte celular. A CytK é uma proteína formadora de poros mais relacionada com outras hemolisinas.
Foi pensado anteriormente que o momento da produção de toxina poderia ser o responsável por dois comportamentos diferentes da doença, mas, de fato, a síndrome emética é causada por uma toxina chamada cereulide que é encontrada apenas em cepas eméticas e não é parte da "caixa de ferramentas padrão" da B. cereus. A cereulide é um polipeptídeo cíclico contendo 3 repetições de 4 aminoácidos: D-oxi-Le-D-Ala-L-oxi-Val-L-Va (semelhante à valinomicina produzida pela Streptomyces griseus), produzida pela síntese de peptídeos não-ribossomais (PNR). Acredita-se que a cereulide se liga aos receptores de serotonina 5-hidroxitriptamina 3 (5-HT3), ativando-os e levando à uma estimulação do nervo vago aferente aumentada.[14] Foi mostrado independentemente por dois grupos de pesquisa a ser codificados em vários plasmídeos: o pCERE01[15] ou pBCE4810.[16] O plasmídeo pBCE4810 [16] compartilha a homologia pBCE4810 com o Bacillus anthracis a virulência do plasmídeo pXO1, que codifica a toxina antraz. Isolados periodontais de B. cereus também possuem distintos plasmídeos parecidos com o pXO1. Como a maioria dos peptídeos cíclicos contendo aminoácidos não-proteinogênicos, a cereulide é resistente à saúde, proteólise e condições ácidas.[17]
A B. cereus também é conhecida por causar infecções crónicas da pele que são difíceis de erradicar embora seja menos agressiva do que a fasciite necrosante. A B. cereus também pode causar ceratite.[18] É mencionada como microflora patogênica em produtos farmacêuticos orais na farmacopeia brasileira [carece de fontes].
Diagnóstico
Em caso de doenças transmitidas por intoxicação alimentar, o diagnóstico de B. cereus pode ser confirmado pelo isolamento de mais de 105 organismos B. cereus por grama de alimento epidemiologicamente implicado, mas essa experiência muitas vezes não é feita porque a doença é relativamente inofensiva e normalmente auto-limitante.[19]
Prognóstico
As doenças transmitidas por alimentos de B. cereus geralmente são auto-limitantes.[19] A maioria dos pacientes eméticos se recupera dentro de 6 a 24 horas,[12] mas em alguns casos, a toxina pode ser fatal.[20][21][22][23][24]
Referências
- ↑ Ryan KJ; Ray CG (editores) (2004). Sherris Medical Microbiology 4 ed. [S.l.]: McGraw Hill. ISBN 0-8385-8529-9
- ↑ Asaeda, Glenn; Caicedow, Gilbert; Swanson, Christopher (dezembro de 2005). «Fried Rice Síndrome» 12 ed. Journal of Emergency Medical Services. 30: 30-32. ISSN 0197-2510. Consultado em 13 de setembro de 2011
- ↑ Vilà, B; A. Fontgibell, I. Badiola, E. Esteve-Garcia, G. Jiménez, M. Castillo and J. Brufau (2009). «Reduction of Salmonella enterica var. Enteritidis colonization and invasion by Bacillus cereus var. toyoi inclusion in poultry feeds». HighWire Press. Poultry Science. 88 (55): 975–9. PMID 19359685. doi:10.3382/ps.2008-00483. Consultado em 14 de maio de 2009
- ↑ Bories, Georges; Paul Brantom, Joaquim Brufau de Barberà, Andrew Chesson, Pier Sandro Cocconcelli, Bogdan Debski, Noël Dierick, Jürgen Gropp, Ingrid Halle, Christer Hogstrand, Joop de Knecht, Lubomir Leng, Sven Lindgren, Anne-Katrine Lundebye Haldorsen, Alberto Mantovani, Miklós Mézes, Carlo Nebbia, Walter Rambeck, Guido Rychen, Atte von Wright and Pieter Wester (9 de dezembro de 2008). «Safety and efficacy of the product Toyocerin (Bacillus cereus var. toyoi) as feed additive for rabbit breeding does - Scientific Opinion of the Panel on Additives and Products or Substances used in Animal Feed» (PDF). European Food Safety Authority. EFSA-Q-2008-287. Consultado em 14 de maio de 2009
- ↑ Bories, Georges; Paul Brantom, Joaquim Brufau de Barberà, Andrew Chesson, Pier Sandro Cocconcelli, Bogdan Debski, Noël Dierick, Anders Franklin, Jürgen Gropp, Ingrid Halle, Christer Hogstrand, Joop de Knecht, Lubomir Leng, Anne-Katrine Lundebye Haldorsen, Alberto Mantovani, Miklós Mézes, Carlo Nebbia, Walter Rambeck, Guido Rychen, Atte von Wright and Pieter Wester. «Opinion of the Scientific Panel on Additives and Products or Substances used in Animal Feed on the safety and efficacy of the product Toyocerin (Bacillus cereus var. Toyoi) as a feed additive for sows from service to weaning, in accordance with Regulation (EC) No 1831/2003» (PDF). European Food Safety Authority. Consultado em 14 de maio de 2009
- ↑ Kotiranta A, Lounatmaa K, Haapasalo M (2000). «Epidemiology and pathogenesis of Bacillus cereus infections». Microbes Infect. 2 (2): 189–98. PMID 10742691. doi:10.1016/S1286-4579(00)00269-0
- ↑ . Turnbull PCB (1996). Bacillus. In: Baron's Medical Microbiology (Barron S et al., eds.) 4th ed. [S.l.]: Univ of Texas Medical Branch. ISBN 0-9631172-1-1. (via NCBI Bookshelf)
- ↑ a b c Roberts, T. A.; Baird-Parker, A. C.; Tompkin, R. B. (1996). Characteristics of microbial pathogens. London: Blackie Academic & Professional. p. 24. ISBN 0-412-47350-X. Consultado em 25 de novembro de 2010
- ↑ McKillip JL (2000). «Prevalence and expression of enterotoxins in Bacillus cereus and other Bacillus spp., a literature review». Antonie Van Leeuwenhoek. 77 (4): 393–9. PMID 10959569. doi:10.1023/A:1002706906154
- ↑ Davis, Judi Ratliff; Lawley, Richard; Davis, Judy; Laurie Curtis (2008). The food safety hazard guidebook. Cambridge, UK: RSC Pub. p. 17. ISBN 0-85404-460-4. Consultado em 25 de novembro de 2010
- ↑ a b c «Bacillus cereus». Todar's Online Textbook of Bacteriology. Consultado em 19 de setembro de 2009
- ↑ a b Ehling-Schulz M, Fricker M, Scherer S (2004). «Bacillus cereus, the causative agent of an emetic type of food-borne illness». Mol Nutr Food Res. 48 (7): 479–87. PMID 15538709. doi:10.1002/mnfr.200400055
- ↑ Guinebretière MH, Broussolle V, Nguyen-The C (2002). «Enterotoxigenic Profiles of Food-Poisoning and Food-Borne Bacillus cereus Strains». J. Clin. Microbiol. 40 (8): 3053–6. PMC 120679
. PMID 12149378. doi:10.1128/JCM.40.8.3053-3056.2002
- ↑ Agata N, Ohta M, Mori M, Isobe M (1995). «A novel dodecadepsipeptide, cereulide, is an emetic toxin of Bacillus cereus». FEMS Microbiol Lett. 129 (1): 17–20. PMID 7781985. doi:10.1016/0378-1097(95)00119-P
- ↑ Hoton FM, Andrup L, Swiecicka I, Mahillon J (2005). «The cereulide genetic determinants of emetic Bacillus cereus are plasmid-borne». Microbiology. 151 (7): 2121–4. PMID 16000702. doi:10.1099/mic.0.28069-0
- ↑ a b Ehling-Schulz M, Fricker M, Grallert H, Rieck P, Wagner M, Scherer S (2006). «Cereulide synthetase gene cluster from emetic Bacillus cereus: Structure and location on a mega virulence plasmid related to Bacillus anthracis toxin plasmid pXO1». BMC Microbiol. 6. 20 páginas. PMC 1459170
. PMID 16512902. doi:10.1186/1471-2180-6-20
- ↑ Stenfors Arnesen LP, Fagerlund A, Granum PE (2008). «From soil to gut: Bacillus cereus and its food poisoning toxins». FEMS Microbiol Rev. 32 (4): 579–606. PMID 18422617. doi:10.1111/j.1574-6976.2008.00112.x
- ↑ Pinna A; Sechi LA; Zanetti S; et al. (2001). «Bacillus cereus keratitis associated with contact lens wear». Ophthalmology. 108 (10): 1830–4. PMID 11581057. doi:10.1016/S0161-6420(01)00723-0
- ↑ a b Bacillus cereus Food Poisoning Associated with Fried Rice at Two Child Day Care Centers from Morbidity and Mortality Weekly Report from Centers for Disease Control and Prevention. March 18, 1994 / Vol. 43 / No. 10 U.S.
- ↑ Takabe F, Oya M (1976). «An autopsy case of food poisoning associated with Bacillus cereus». ForensicSci. 7 (2): 97–101
- ↑ Mahler H; et al. (1997). «Fulminant liver failure in association with the emetic toxin of Bacillus cereus». N Engl J Med. 336 (16): 1142–1148. PMID 9099658. doi:10.1056/NEJM199704173361604
- ↑ Dierick K; et al. (2005). «Fatal family outbreak of Bacillus cereus-associated food poisoning». J Clin Microbiol. 43 (8): 4277–4279. doi:10.1128/JCM.43.8.4277-4279.2005
- ↑ Shiota, M; et al. (2010). «Rapid Detoxification of Cereulide in Bacillus cereus Food Poisoning». Pediatrics. 125 (4): e951-e955. doi:10.1542/peds.2009-2319
- ↑ Naranjo, M; et al. (2011). «Sudden Death of a Young Adult Associated with Bacillus cereus Food Poisoning». J Clin Microbiol. 49 (12): 4379–4381. doi:10.1128/JCM.05129-11
Ligações externas
- Bacillus cereus genomas e informação relacionada em Patric, um Centro de Recursos de Bioinformática financiado pela NIAID